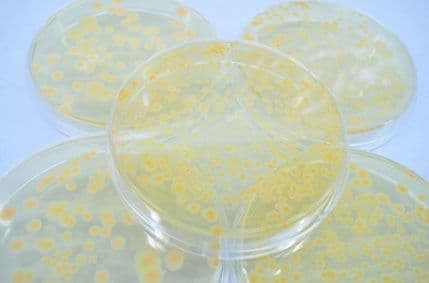
Naučnici tvrde da su otkrili dokaz vanzemaljskog života Naučnici tvrde da su otkrili dokaz vanzemaljskog života

Tim naučnika poslao je balon do visine od 27 kilometara u stratosferu koji je uspio da uhvati male biološke organizme za koje tvrde da su mogli da dođu samo iz svemira.
Grupa koju je predvodio astrobiolog profesor Čandra Vikramasinge, tvrdi da je „sjeme života“ transportovano između planeta od strane prolazećih meteora, prenosi b92.
Naučnici su za ovu priliku dizajnirali poseban balon koji je poslat u atmosferu tokom meteorskog pljuska Perseidi. Balon je prenosio sterilne mikroskopske pločice koje su izložene atmosferi tek na visini od 27 kilometara.
Kada je balon pao na Zemlju, naučnici su otkrili mikrosopske vodene alge koje mogu biti samo vanzemaljskog porijekla. Njihovo otkriće prezentovano je prošlog mjeseca na konferenciji u San Dijegu.
„Ono što smo otkrili variralo je od ultra malih bakterija pa sve do dva neobična organizma“, izjavio je profesor Vikramasinge.
On smatra da ovo otkriće ide u prilog teoriji pod nazivom panspermija koja pretpostavlja da je život na Zemlju stigao iz svemira.
Skeptici vjeruju da su „biološki entiteti“ koji su uhvaćeni u stratosferi tamo stigli sa Zemlje, ali profesor Vikramasinge tvrdi da to nije moglo da se desi.
„Po našem razumjevanju načina na koji takve čestice mogu biti prenijete u stratosferu to nije moglo da se desi – da bi se nešto tako desilo bila bi potrebna agresivna erupcija vulkana na dan slanja balona, a to se nije desilo. Ukoliko nije bilo mehanizama uz pomoć kojih bi ti biološki entiteti stigli do stratosfere sa Zemlje, onda je logičan zaključak da su oni do stratosfere stigli iz svemira“.
Foto: Image courtesy of Photokanok